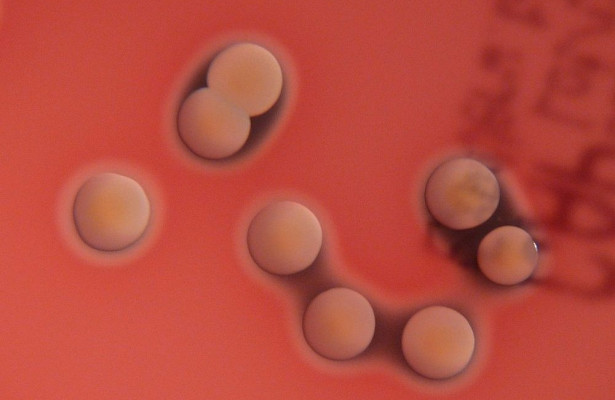
Марганец помогает стафилококку убивать сердце

Ученые из США выяснили, что еда с большим количеством марганца делает сердце уязвимым для инфекции. Ученые исследовали золотистый стафилококк. Известно, что этот микроб — основной инициатор внутрибольничных инфекций и умеет защищаться от антибиотиков (причем, умел это делать еще до того, как антибиотики появились). Стафилококк вызывает много разных заболеваний, одно из них — инфекционный эндокардит, или […]

 Новость из категории
Новость из категории  Метки:
Метки: 

